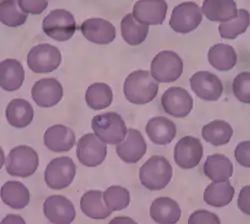

Trofozoíto
Un trofozoíto es la forma vegetativa activada que se alimenta —generalmente por fagocitosis— y se reproduce, a diferencia del quiste que es la forma vegetativa infectante y de resistencia, en el ciclo de vida de los microorganismos protozoarios.
Por ejemplo, los trofozoítos del género Plasmodium (responsables de la malaria o paludismo) invaden los glóbulos rojos y se alimentan de las proteínas contenidas en estos.
En algunas especies, los trofozoítos no enquistan; por ejemplo, Dientamoeba fragilis, Pentatrichomonas hominis y Trichomonas, de modo que el trofozoíto es la única forma de vida del parásito. Los trofozoítos tienen dos núcleos en los ciliados.
Morfología
Se caracterizan por tener uno o dos núcleos con una concentración de cromatina llamada cariosoma, la cual puede ser concéntrica o en la periferia del núcleo. Instalados en un hospedador, los trofozoítos pueden ser patógenos (por ejemplo en la disentería amebiana), mientras que otros pueden no ser patógenos (como lo es la forma natural de la Entamoeba histolytica). Algunos tienen seudópodos, aparato de Golgi, lisosomas, ribosomas,[1] retículo endoplasmático, vacuolas digestivas, mitocondria y, en algunos casos (Acanthamoeba castellanii), un sistema de canalículas para expulsar el exceso de agua.[2]
Referencias
- RIVERA, María, DE LA PARTE, María A, HURTADO, Pilar et al. Giardiasis Intestinal. Mini-Revisión. Invest. clín. [online]. abr. 2002, vol.43, no.2 [citado 4 de octubre de 2007], p.119-128. Disponible en la World Wide Web: . ISSN 0535-5133.
- Blair Bowers, Edward D. Korn. The fine structure of Acanthamoeba castellanii : I. The Trophozoite. The Journal of Cell Biology, Vol 39, 95-111.